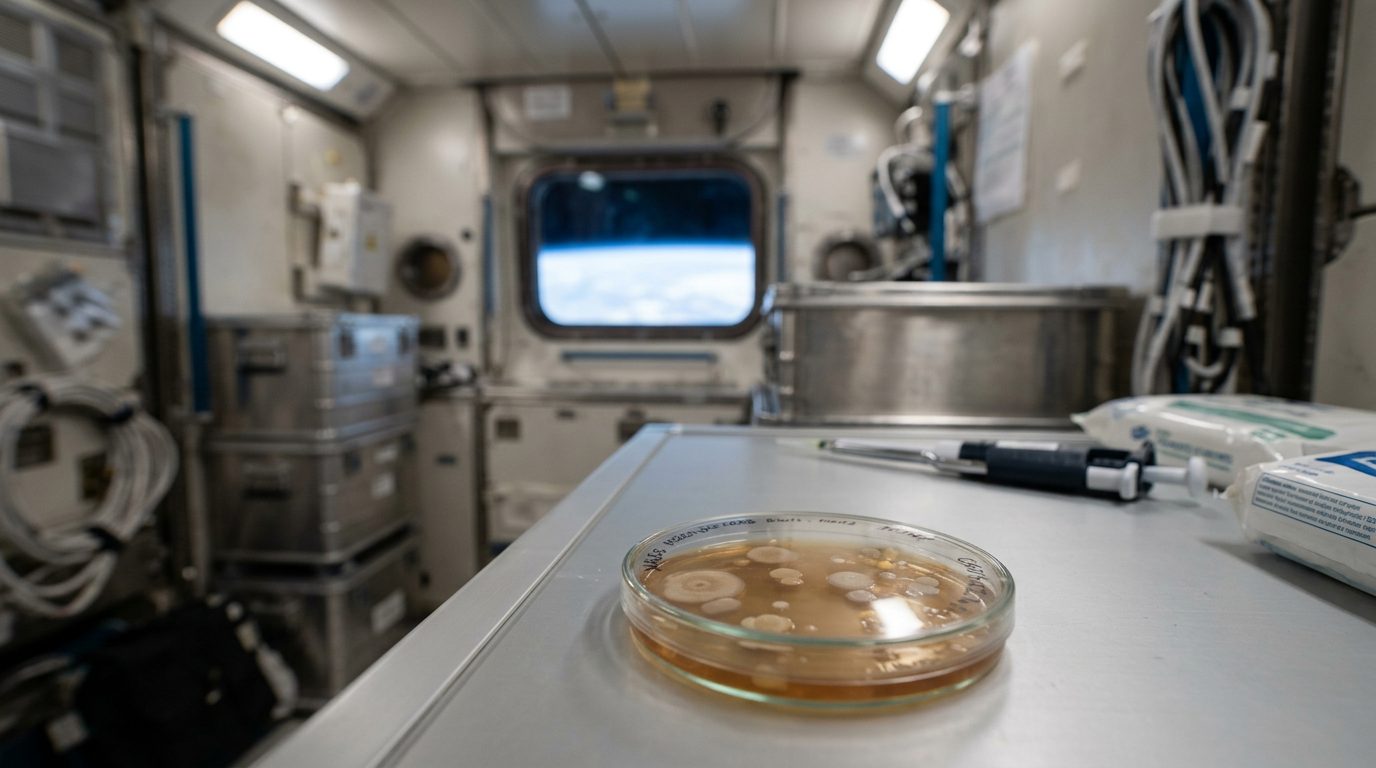
ISS astronauts' bacteria have evolved into new strains, pictured in a lab setting.

Quick Answer
Bacteria on the International Space Station have evolved into strains never seen before on Earth.
Sources & References
- 1NASANASA's Ames Research Center conducted a study finding that bacteria isolated from the International Space Station (ISS) were not more virulent than their Earth counterparts, although they showed genetic adaptations.nasa.gov
- 2MicrobiomeA study published in the journal Microbiome analyzed five years of microbial data from the ISS, revealing the presence of a persistent, multi-drug resistant bacterium, Enterobacter bugandensis, which had evolved unique resistance mechanisms.microbiomejournal.biomedcentral.com
- 3Phys.orgPhys.org reported that a new study identified two common bacteria, Staphylococcus aureus and Enterobacter bugandensis, that have adapted to the ISS environment and diversified into genetically distinct strains.phys.org
- Small TalkLearn more about the International Space Station, the orbital laboratory where these bacterial studies take place.getsmalltalk.com